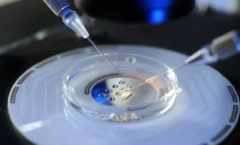
南昌农村试管3万补助真相揭秘：最新政策解读

试管费用

-
 衢州三代试管生育男孩费用揭秘:明细表助您合理规划预算!
衢州三代试管生育男孩费用揭秘:明细表助您合理规划预算!三代试管生男孩的总体费用受地区、医院级别及具体服务内容等多种因素影响,普遍而言,涵盖了医院手术费、药物治疗费及试管核心技术的费用,整体预算大致在30万至50万元人民币之间
作者:婷婷 172 发布时间:2025-11-26 -
 邯郸三代试管揭秘:单周期费用曝光,10万预算轻松应对!
邯郸三代试管揭秘:单周期费用曝光,10万预算轻松应对!邯郸三代试管的费用大概在十万左右这个价格包含了许多方面的费用。首先是医疗费用,包括体外受精技术、胚胎移植等医疗操作的费用。其次是药物费用,因为进行试管需要使用一
作者:婷婷 172 发布时间:2025-11-26 -
 柬埔寨三代试管:30万预算够不够?一文速览全部费用!
柬埔寨三代试管:30万预算够不够?一文速览全部费用!30万人民币确实足够支付柬埔寨三代试管一次的全部费用。柬埔寨的试管费用在全球范围内属于较低水平,这使得30万人民币可以涵盖诊疗、药物和其他相关费用。这一价格虽然对许多
作者:婷婷 165 发布时间:2025-11-26 -
 人工受孕全解析:五大费用方面,总成本约10万元,一文速览!
人工受孕全解析:五大费用方面,总成本约10万元,一文速览!作为一种辅助生育技术,人工受孕在现代已经得到广泛应用。但是由于涉及到各种医疗、技术和药品等方面的成本,人工受孕的费用也成为了备受关注的话题。那么究竟人工受孕需要花费多少
作者:婷婷 139 发布时间:2025-11-26 -
 试管费用新选择!哈尔滨两家私立医院,价格亲民不超10万!
试管费用新选择!哈尔滨两家私立医院,价格亲民不超10万!选择优质的私立医院进行试管治疗至关重要。在哈尔滨,多家私立医院中,哈尔滨玛丽亚生殖中心与哈尔滨三博莱生殖中心等以其出色的知名度和良好口碑脱颖而出。这些医院配备了尖端医
作者:木易 163 发布时间:2025-11-26 -
 宁夏私立医院哪家最优秀?银川生殖医院费用明细,任您挑选!
宁夏私立医院哪家最优秀?银川生殖医院费用明细,任您挑选!宁夏地区试管服务中,众多家庭尤为关注私立医院的手术费用。在宁夏,数家私立医院均提供试管服务,但价格存在差异。据我所知,银川生殖医院是宁夏地区备受推崇的私立医院之一
作者:木易 196 发布时间:2025-11-26 -
南昌农村试管3万补助真相揭秘:最新政策解读
南昌农村试管3万补助真相揭秘:最新政策解读根据我的调查研究,关于2023年南昌农村做试管可以获得3万补助的说法并不属实。截至目前没有任何官方消息或政策文件证实了这一说法。因此我们应该对这个标题持怀疑态度。 试管
作者:婷婷 57 发布时间:2025-11-26 -
 安徽省立医院试管包男孩服务介绍及费用构成
安徽省立医院试管包男孩服务介绍及费用构成安徽省立医院是一家专业从事试管技术的私人医院。试管是一种辅助生殖技术,通过体外受精和胚胎移植,帮助无法自然受孕的夫妇实现生育梦想。对于那些希望生育男孩的夫妇来说
作者:盼盼 135 发布时间:2025-11-26 -
 试管促排移植费用不再迷茫!省钱攻略在手,速览指南
试管促排移植费用不再迷茫!省钱攻略在手,速览指南随着现代医学技术的不断发展,越来越多的夫妇选择了试管技术来实现生育愿望。在试管技术中,促排和胚胎移植是非常重要的步骤。那么促排和胚胎移植费用到底是多少呢? 试管促排
作者:木易 172 发布时间:2025-11-26 -
 全面了解南宁三代试管双胞胎费用,证件准备攻略不容错过!
全面了解南宁三代试管双胞胎费用,证件准备攻略不容错过!南宁三代试管双胞胎费用涵盖医疗与证件准备两部分。医疗开销涉及全面检查、个性化促排卵、取卵手术、胚胎培养及移植等,总费用约7万至15万人民币,因个体情况而异,双胞胎治疗可能需额
作者:雨诗 179 发布时间:2025-11-26 -
 全国试管费用公布:医院选择决定你的经济负担!
全国试管费用公布:医院选择决定你的经济负担!试管技术是一种辅助生殖技术,适用于无法通过自然方式怀孕的夫妇。但是试管手术费用通常很高,这让很多人望而却步。那么全国试管总费用如何呢? 全国试管不同地区和医
作者:木易 183 发布时间:2025-11-26 -
 山东济南第三代试管价位如何?详细报价现已公布!
山东济南第三代试管价位如何?详细报价现已公布!济南三代试管费用公布,个性化报价满足多样需求。通常,该费用区间大致在20万至50万人民币之间,具体金额会根据一系列因素灵活调整。这些因素涵盖了所选择的医院级别、医生的临床经验
作者:雨诗 121 发布时间:2025-11-26
